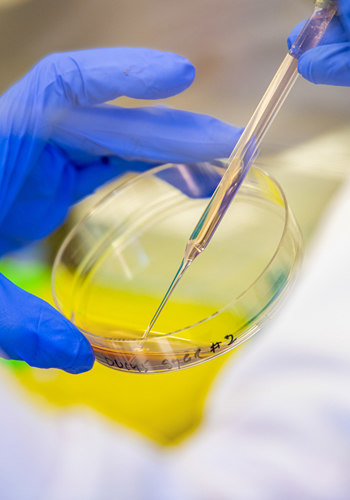
...

Science
An unparalleled approach
At Cleveland Clinic, researchers and physicians share a common mission: challenging the status quo for patient care. Our scientists have unrivaled access to patient samples and data, and work in collaboration with top-ranked physicians. Patients benefit when our teams work together.
Departments & CentersHealthcare research doesn't stop at the bedside.
"Bench to bedside" describes how lab discoveries are incorporated into patient care at Cleveland Clinic. Doctors at the bedside share clinical insights from patients directly with researchers, leading to patient-focused research projects. This shared perspective leads to cutting-edge care.
How research fuels care
Our Departments
Our departments are composed of multidisciplinary teams that study specific disease areas or approaches to advance scientific understanding of disease processes and develop new therapeutics, diagnostics and medical devices.
Our Centers & Programs
Our centers and programs extend research efforts across departments and institutes to accelerate breakthroughs relevant to patient care.
Research Technology & Services
Cleveland Clinic Research's state-of-the-art cores and facilities offer investigators advanced technologies, equipment and expertise to support laboratory, translational and clinical research.
Explore Cores